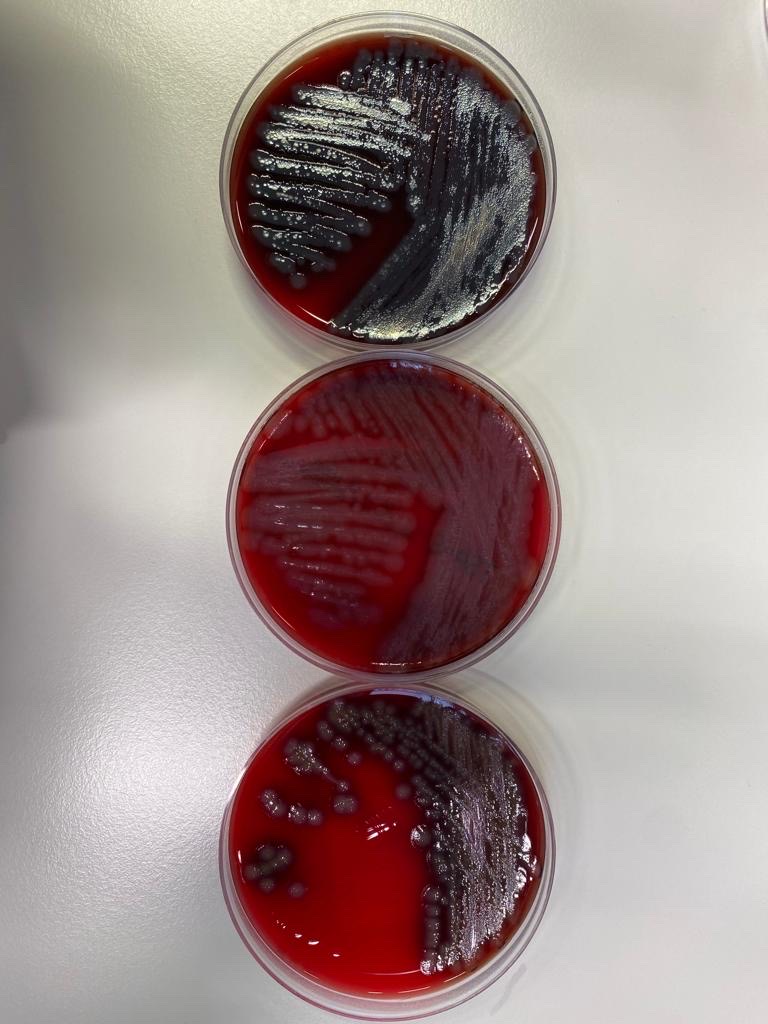
Exciting news!! Collection of CR-PA isolates from patients, healthy humans, the hospital environment, and water has finished in Jakarta (Indonesia) and Rotterdam (The Netherlands), and is in full swing in Rome (Italy)!

SAMPAN Project
@sampan_project
This project aims to develop a smart surveillance strategy for carbapenem-resistant Pseudomonas aeruginosa (@JPIAMR, @ZonMw, @CIHR funded).
ID: 1549723601653448704
https://www.erasmusmc.nl/en/research/projects/sampan 20-07-2022 11:51:33
6 Tweet
9 Takipçi
49 Takip Edilen

Welcome to the official Twitter account of SAMPAN Project! This project is an international collaboration between institutes in Canada, Indonesia, Italy and the Netherlands. Our aim is to develop a smart surveillance strategy for carbapenem-resistant Pseudomonas aeruginosa.

Onderzoekers van het Erasmus MC doen onderzoek naar de aanwezigheid van de #Pseudomonas-bacterie. Bent u benieuwd of u deze bacterie heeft? Woont u in Rotterdam en bent u niet opgenomen in een ziekenhuis? Doe mee aan het SAMPAN Project! Meer informatie: erasmusmc.nl/nl-nl/patiente…


Onderzoekers van het Erasmus MC doen onderzoek naar de aanwezigheid van de Pseudomonas-bacterie. Bent u benieuwd of u deze bacterie heeft? Woont u in Rotterdam en bent u niet opgenomen in een ziekenhuis? Doe mee aan het SAMPAN Project! Meer informatie: erasmusmc.nl/nl-nl/patiente…